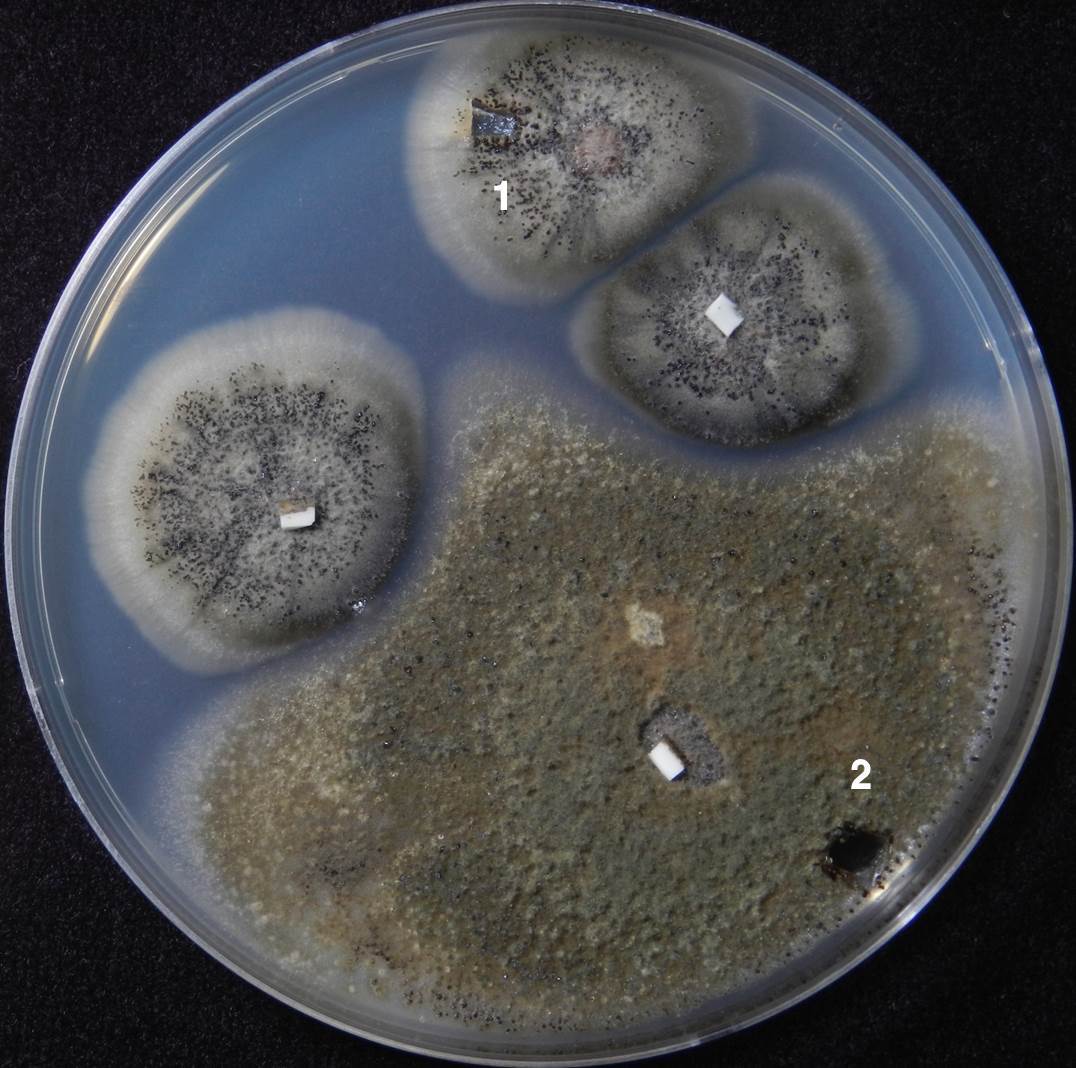
그림8.jpg
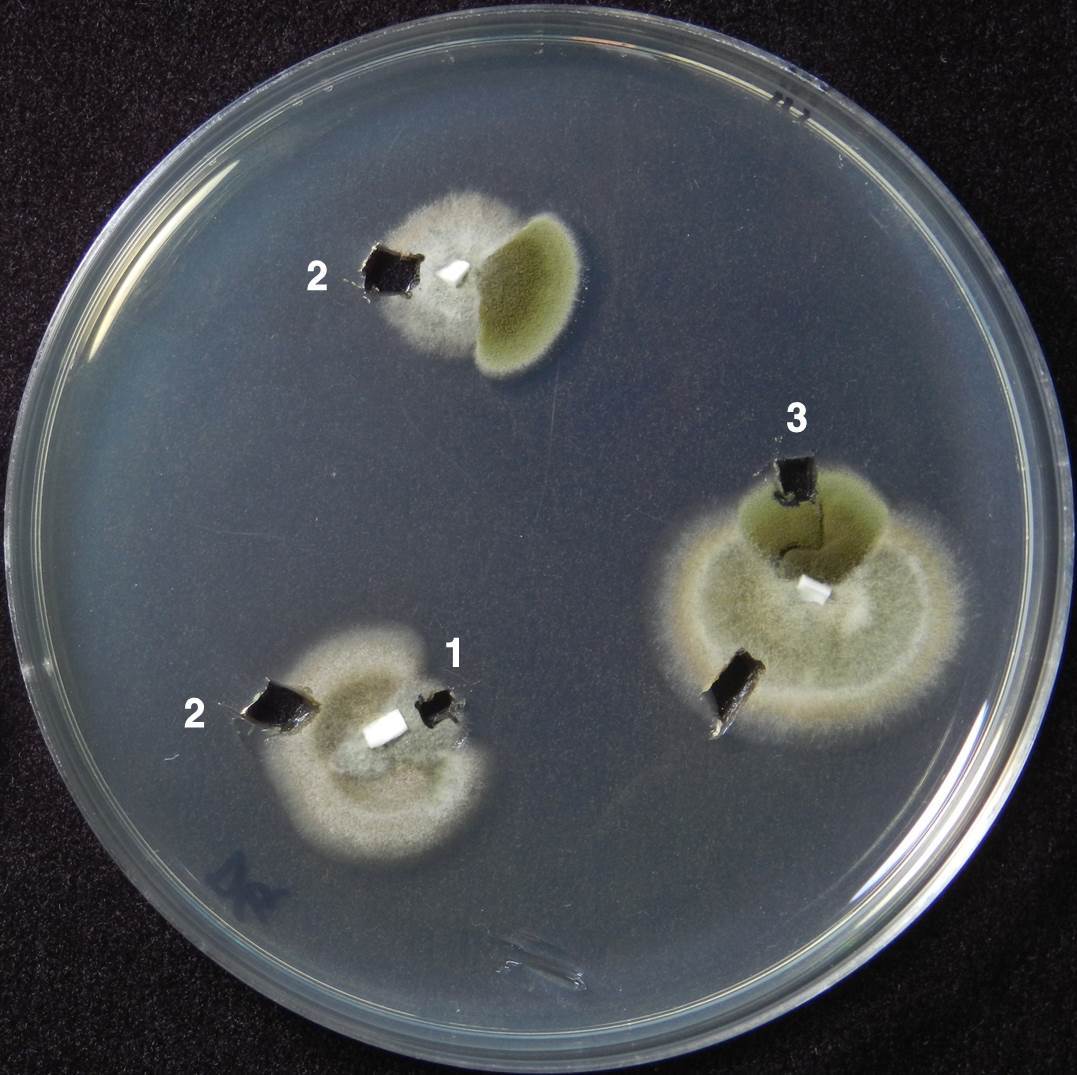
그림9.jpg
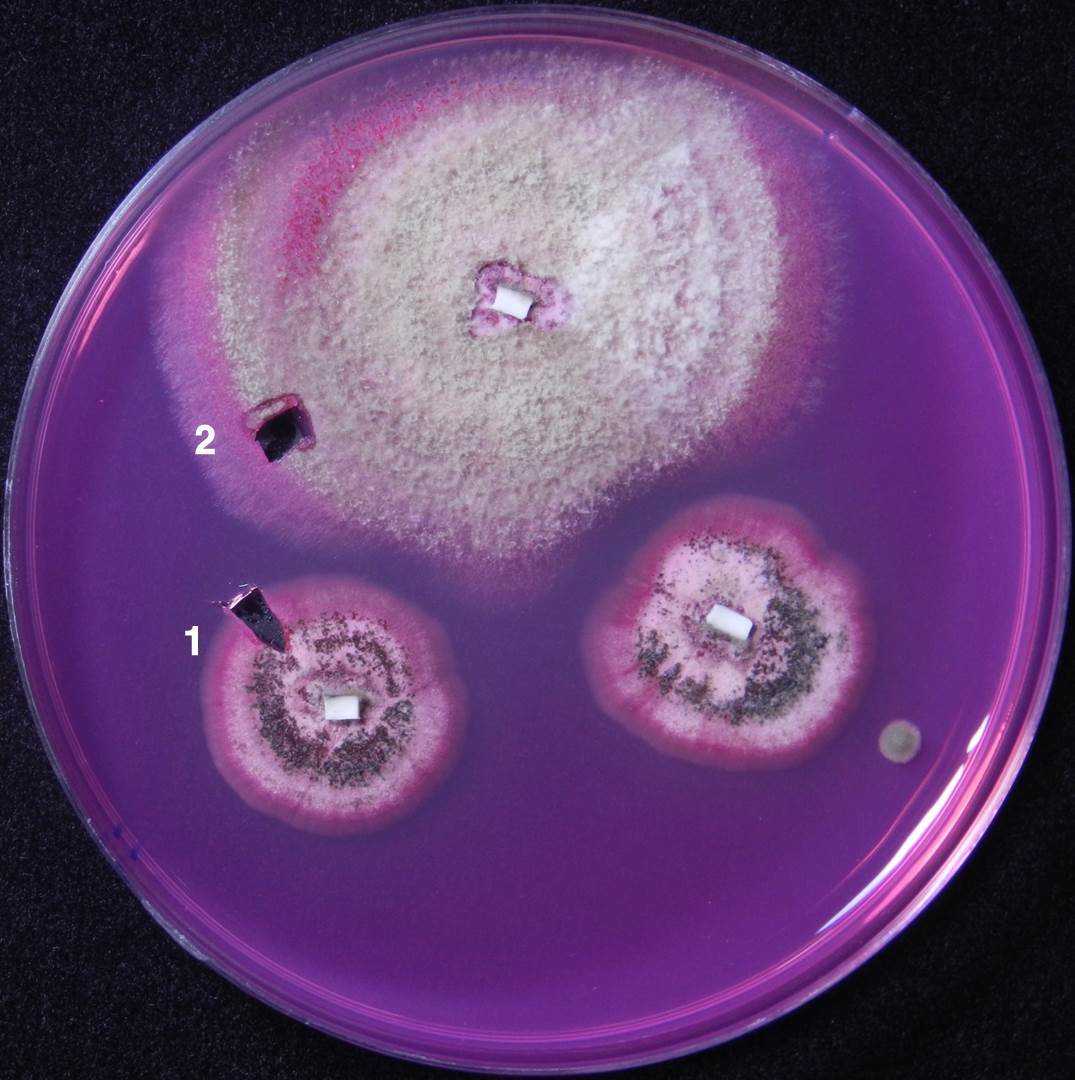
그림10.jpg

세면대 실리콘 곰팡이
곰팡이이야기 14 (생활속의 곰팡이 1)
곰팡이 하면 눅눅함, 습기, 물기가 생각난다. 집에서 물기가 많은 곳은 주방과 욕실이다. 이 중 주방은 곰팡이가 자라기엔 너무 자주 닦고 말리고 하니 곰팡이가 근접하기 어렵고 욕실은 왠지 곰팡이와 어울릴 수 있는 조합이다.
욕실엔 변기, 세면대, 샤워기, 욕조가 있지만 방수 처리된 토기 들이다. 또한 벽면도 물기로부터 보호하기 위하여 타일을 사용한다. 욕실 어디에 곰팡이가 자라? 얼핏 보기엔 곰팡이가 발붙일 곳이 없을 듯하지만 자세히 보면 세면대와 벽사이 그리고 욕조와 벽사이에 이들을 고정하기 위하여 사용한 실리콘(silicone)이 있다.
플라스틱을 먹어치우는 곰팡이도 있단다. 그런데 몰랑몰랑한 실리콘쯤이야. 공기 중엔 먹을 꺼리가 없나 호시탐탐 노리는 수십종의 곰팡이가 있다. 먹을꺼리가 있고 온도와 습도의 환경만 맞으면 곰팡이는 언제든지 자리를 잡고 실을 내어 자란다. 욕실의 실리콘은 이런 요건들을 갖췄다.
실리콘 곰팡이의 관찰과 순수분리
2013년 여름. 수원의 매탄주공5단지의 우리집(내집) 세면대 실리콘에도 그분이 오셨다. 귀한 손님이라 내쫓지 않고 오히려 좋은 환경을 만들어 드렸더니 충분히 그리고 이쁘게 자라셨다. 심기를 건드리지 않고 칼로 예쁘게 오려서 실험실로 모시고 왔다.

 논문 홍등(2014)의 사진 인용
논문 홍등(2014)의 사진 인용
먼저 해부현미경으로 곰팡이가 슨 실리콘 부위를 관찰하였다. 곰팡이는 실리콘의 겉면에만 자란 것이 아니라 내부에까지 침투하였다(그림 4.). 0.2mm까지 침투하였는데 이것이 실리콘에 핀 곰팡이의 제거를 어렵게 한다(그림 5). 실리콘 표면에 생긴 곰팡이층을 긁어내어 광학현미경으로 관찰했다. 풍부한 곰팡이실(균사)이 관찰되었고 그 사이로 둥근 분생포자열매( Pycnidia, 병자각)도 다수 관찰되었다(그림 6).
 그림 4. 세면대 실리콘의 평면과 단면, 실체현미경 10배 촬영(논문 홍등 2014 사진 인용)
그림 4. 세면대 실리콘의 평면과 단면, 실체현미경 10배 촬영(논문 홍등 2014 사진 인용)
 그림 5. 세면대 실리콘 단면 50배 사진, 점선 아래의 검은 부분이 곰팡이가 슨 부분이다. 0.2mm까지 곰팡이가 자랐다.
그림 5. 세면대 실리콘 단면 50배 사진, 점선 아래의 검은 부분이 곰팡이가 슨 부분이다. 0.2mm까지 곰팡이가 자랐다. 그림 6. 세면대 실리콘 곰팡이의 광학현미경 사진. 갈색의 곰팡이 실 사이에 둥근 모양의 분생포자열매(pycnidia)가 보인다. 이 열매로 인하여 곰팡이는 락스에도 버틴다.
그림 6. 세면대 실리콘 곰팡이의 광학현미경 사진. 갈색의 곰팡이 실 사이에 둥근 모양의 분생포자열매(pycnidia)가 보인다. 이 열매로 인하여 곰팡이는 락스에도 버틴다.실리콘에 발생한 곰팡이를 더 깊이 조사하기 위하여 순수분리를 시도하였다. 곰팡이가 발생한 실리콘 조각을 좋아하는 먹이가 들어있는 밀봉된 페트리 접시(배양기)에 올려놓고 잘 자랄 수 있는 분위기를 조성해 주었다. 일주일이 지나자 실리콘이라는 열악한 환경에서 부시시한 모습으로 자랐던 그 분들이 좋은 환경에서 제대로된 모습을 보여 주셨다.
 그림 7. PDA 배지위에 실리콘을 옮기고 7일간 배양한 사진. 구멍 뚫린 부분은 더 자세한 관찰을 위하여 곰팡이를 새로운 배지로 옮긴 부분. (홍등 2014 논문 사진 인용)
그림 7. PDA 배지위에 실리콘을 옮기고 7일간 배양한 사진. 구멍 뚫린 부분은 더 자세한 관찰을 위하여 곰팡이를 새로운 배지로 옮긴 부분. (홍등 2014 논문 사진 인용)
 그림 8. DG18이란 배지에 실리콘을 올려 놓고 7일간 배양 시켰다. (논문 홍등 2014 사진 인용)
그림 8. DG18이란 배지에 실리콘을 올려 놓고 7일간 배양 시켰다. (논문 홍등 2014 사진 인용) 그림 9. DRBC라는 배지에 곰팡이가 슨 실리콘을 올려놓고 7일간 배양한 결과이다. (논문 홍등 2014 사진 인용)
그림 9. DRBC라는 배지에 곰팡이가 슨 실리콘을 올려놓고 7일간 배양한 결과이다. (논문 홍등 2014 사진 인용)서로 다른 환경에서(즉 서로 다른 먹이에서) 그 분들은 각기 다른 모습으로 자랐으나 내집의 세면대 실리콘을 방문한 곰팡이는 3분(3 종, species)이었다. 이들을 별도의 방으로 모신 다음에 정밀조사에 착수하였다. 현미경으로 샅샅이 조사하고 피를 뽑아서 유전자 검사까지 며칠간 밤샘 조사하였다. 결국 그 분들의 정체를 밝혔는데
세면대 실리콘에 발생한 곰팡이의 정체는?
1번 곰팡이는(그림 7,8,9의 1번에서 떼어낸 곰팡이) Phoma herbarum으로, 2번은 Dydimella heteroderae로, 3번은 Cladosporium halotolerans로 밝혀졌다. 이 중에서는 3번은 분리 빈도가 낮았고 주를 차지한 것은 1번과 2번이었다.
이들에 대하여 자세하게 소개하면,
1번 Phoma herbarum (KACC 47610).
물, 토양, 초본류와 목본류, 그리고 열대에서 한대에 이르기까지 세계 어디에서든 자라는 매우 흔한 곰팡이이다. 귀리의 씨앗에서 약한 병원성을 나타내기는 하였지만 경제적 영향력이 미약하고 일반적으로 죽은 식물체를 분해하는 부생균으로 알려져 있다(Domsch 등, 2007). 연어에서는 병을 일으키기도 했으나 사람에서는 피부나 호흡기에서 분리되기는 하였으나 병원성은 의문시 된다. 생물안전 1등급으로 대장균(Escherichia coli), 고초균(Bacillus subtilis), 효모(Saccharomyces cerevisiae)와 같은 생물안전성 등급이다.
18-25℃에서 잘 자라고 산소가 없는 곳에서도 다소 자랄 수 있다. 인공배지에 배양할 때에 기중균사는 드물고 많은 분생포자열매(Pycnidia)를 맺는데 그 안에 끈적끈적한 포자를 만들고 익으면 배출한다.
 그림 10. Phoma herbarum, KACC 47610. 왼쪽이 분생포자열매(Pycnidium) 오른쪽이 분생포자이다(홍등 2014 논문 사진 인용).
그림 10. Phoma herbarum, KACC 47610. 왼쪽이 분생포자열매(Pycnidium) 오른쪽이 분생포자이다(홍등 2014 논문 사진 인용).
2번 Didymella heteroderae (KACC 47611, 47612).
원래 이름은 Phoma heteroderae 였으나 2015년에 Dydimella heteroderae로 바뀌었다(Chen 등, 2015, 2017) . 즉 이 곰팡이는 처음에는 Phoma 속으로 생각했을 정도로 위의 Phoma herbarum과 매우 가깝고 많은 특성을 공유한다. 이 곰팡이 역시 많은 분생포자열매(pycnidia)를 만들고 그 안에 포자를 만든다. 추가로 이곰팡이는 Alternaria의 분생포자와 유사한 벽돌형후벽포자(dictyochlamydospore)를 만든다. 이 곰팡이 역시 전세계적으로 분포하며 다양한 토양과 식품에서 분리되며 식물종자에 병을 내기도 하는 약한 식물병원균으로 간주된다(Aveskamp 등, 2010).
 그림 11. Didymella heteroderae, KACC 47612의 현미경 사진. 왼쪽은 분생포자열매, 중앙은 후벽포자, 오른쪽은 분생포자(홍등 2014 논문 사진 인용)
그림 11. Didymella heteroderae, KACC 47612의 현미경 사진. 왼쪽은 분생포자열매, 중앙은 후벽포자, 오른쪽은 분생포자(홍등 2014 논문 사진 인용)
3번 Cladosporium halotolerans (KACC 47613*).
2016년에 보고된 젊은 종이나 지구상에 널리 분포할 것으로 여겨진다. 소금물, 실내공기, 남극 얼음, 바위, 창틀 등의 다양한 매질로부터 이 종의 분리가 보고되었으나 그 역할에 대하여는 아직 자세하게 보고되지 않았다(홍 등, 2014). 1번과 2번 곰팡이는 속(genus)이 서로 달라 8촌정도 된다면, 3번 곰팡이는 1,2번과는 목(order)이 서로 달라 거의 남이라고 봐도 된다.
그림 12. Cladosporium halotolerans, KACC 47613. 왼쪽과 중앙은 분생포자경 오른쪽은 분생포자(홍등 2014 논문 사진 인용).
그림 12. Cladosporium halotolerans, KACC 47613. 왼쪽과 중앙은 분생포자경 오른쪽은 분생포자(홍등 2014 논문 사진 인용). * KACC는 농업미생물은행(Korean Agricultural Culture Colleciton)의 약자이며 다섯자리 숫자는 해당곰팡이의 주민등록번호이다. 실리콘 곰팡이의 방제 등의 추가연구를 하고자 하는 사람은 해당 번호로 농업미생물은행(http://genebank.rda.go.kr)에 신청하면 무상으로 그림에 있는 바로 이 곰팡이를 분양받을 수 있다.
다른 나라의 실리콘 곰팡이는?
내집의 세면대 실리콘에는 이런 손님들이 왔는데 다른 곳은 어떤지 알아봤다. 우리나라에는 조사된 바가 없었고 서양에서도 찾기 어려웠는데 일본에서 잘 조사된 논문을 찾을 수 있었다. 역시 일본이다. 그것도 학자들이 아니라 세면대와 변기를 만드는 회사인 TOTO社(토토사)에서 연구를 수행하였다(Moriyama 등, 1992).
토토사는 일본 전역의 21개 지역, 63개 가정집과 21개 호텔의 욕실의 곰팡이를 조사하였다. 이들은 실리콘 뿐만이 아니라 벽면과 바닥의 타일, 욕조 등 곰팡이가 발생한 부위를 가능한 모두 조사하였다. 그 결과 Phoma와 Cladosporium 속(genus)은 일본 21개 전역의 욕실에서 분리되었고 Pecnicillium (95%), Alternaria (76%), Arthrinium (62%)이 그 뒤를 이었다.
이들은 또한 욕실 공기 중에 있는 곰팡이 포자를 측정하였다. Cladosporium (100%), Penicillium (100%), Aspergillus (57%) 순이었고 내집 실리콘의 주범이었던 Phoma 속은 24%에 그쳤다.
이 결과는 매우 흥미롭다. 욕실의 공기 중에 존재하는 곰팡이 빈도 순위와 욕실의 실리콘에 존재하는 곰팡이 빈도 순위가 서로 다르다. 실리콘에서 가장 문제가 되고 빈번하게 발생하는 Phoma속은 공기 중에서는 포자 빈도가 높지 않다. 그 이유를 포자를 둘러싸고 있는 포자열매(pycnidia)에서 찾을 수 있다. Phoma는 포자열매라는 주머니 안에다가 끈끈한 포자를 만들기에 공기중으로 쉽게 포자를 방출하지 않는다. 따라서 실리콘에 Phoma가 많드라도 공기중에 Phoma의 포자 밀도가 낮을 수 있다.
또한 곰팡이 마다 좋아하는 먹이가 서로 다르다. Penicillium가 Aspergillus는 공기 중에는 포자가 많지만 기본적으로 먹이로 실리콘을 별로 좋아하지 않는다. 사람도 좋아하는 반찬과 음식이 서로 다르지 않은가?
실리콘 곰팡이는 사람에게 어떤 영향을 미칠까?
실리콘 침범의 주범인 Phoma 속 곰팡이나 Cladosporium 속 곰팡이는 주로 식물병원균이거나 토양균, 식품 오염균 정도이고 사람에게 약한 병을 일으킨다는 보고는 있으나 실제 우려하는 곰팡이는 아니다(Phoma 속은 생물안전1등급)(Phoma herbarum과 Didymella heteroderae가 사람에게 심한 병을 일으키지는 않지만 빈번하게 병을 일으킬 수 있다는 논문도 있었다. Nicomedes, 2016).
실제 Cladosporium은 공기 중에 늘상 있다고 봐야 하는데 이들이 사람에게 병을 일으킨다면 사람이 살아갈 수가 없다. 따라서 세면대 실리콘에 곰팡이가 핀다고 해서 건강 상에 큰 문제를 일으키지는 않는다고 할 수 있겠다. 다만 실리콘에 매우 많은 곰팡이가 발생하여 포자를 공기 중으로 대량방출한다면 노약자나 면역기능에 이상이 있는 사람에게는 천식 등을 유발할 수는 있겠다.
실리콘 곰팡이 청소 방법은?
곰팡이 퇴치에 가장 많이 사용하는 것이 락스다. 락스에는 차아염소산나트륨이 1% 들어있는데 이 성분이 곰팡이를 죽인다. 일본 연구에 의하면 실리콘 표면에 있는 곰팡이는 차아염소산 1%(락스)에 1분만 담구면 모두 죽었다(Hara 등, 2009).
하지만 실리콘 내부로 침투한 곰팡이는 1분간 락스에 담갔을 때도 살아남았고 10분간 담궜을 때에 대부분 죽었다. 다만 Phoma 속 곰팡이가 실리콘 내분에 침입하였을 때에는 10분간 담구어 놓아도 사멸되지 않았다. 저자는 그 이유를 Phoma 속이 포자열매(pycnidia) 안에 포자를 만들기에 락스가 포자열매 안쪽까지 일일이 침투하지 못하기 때문으로 설명하였다(Hara 등, 2009).
실험 결과는 그렇고 실제는 실리콘에 핀 곰팡이의 퇴치를 위하여 그리 고민하지 않아도 된다. 우선 곰팡이가 실리콘에 앉더라도 내부로 자라 들어갈 때까지 두지 말고 닦아 내면 된다. 그저 1주일에 한두번 일반 세정제로 닦아 내면 곰팡이는 자리를 잡지 못할 것이다.
그럼에도 불구하고 어떤 연유로 Phama 곰팡이가 실리콘 안 0.2 mm까지 침입하였다면?
그러면 이들을 퇴치하기 위하여 락스를 10분보다 훨씬 길게 처리하면 된다. 즉 곰팡이가 핀 실리콘에 휴지를 수겹 붙이고 거기에 락스를 촉촉하게 묻혀 놓고 수시간동안 두면 제 아무리 포자열매에 감춰진 포자라도 락스에 몇 시간은 버티지 못한다.
다만 락스는 몸에 좋지 않으니 장갑을 끼고 몸에 닿지 않게 조심하고 락스 냄새 역시 염소로 몸에 좋지 않으니 처리 후에는 환기를 철저히 하여 냄새를 날려버려야 한다는 사실도 명심하여야 한다.
실험에 사용했던 매탄주공5단지 내집의 실리콘의 곰팡이도 락스와 휴지방법으로 깨끗하게 해결했다.
세면대 실리콘 곰팡이가 피었던 매탄주공5단지 아파트.
2009년부터 15년 전주 이사 올때까지 6년 살았다. 큰애들의 초등학교 4학년때부터 중학교 3학년때까지, 한창 성장기에 이 아파트에 살았기에 추억이 많다. 거실에서 효원공원 전체가 한눈에 들어왔고 아파트 앞의 느티나무의 울창한 잎파리들이 내려다 보여 눈이 시원하였다.
아파트 바로 앞에 조그만 상가가 있었는데 거기에 소담치킨이라고 후라이가 특히 맛있는 집이 있었다. 애들이 좋은 성적을 받아오거나 격려해줄 일이 있으면 자주 찾았던 소담치킨. 치킨도 맛있었지만 한잔의 맥주와 함께 듣는 흘러간 팝송도 좋았다. 지금도 그대로 있으려나? 인터넷에 들어가 매탄주공5단지를 기웃거리다가.
헐! 내가 살던 아파트의 거래가가 5억 9천만원. 4년전 이맘때에 내려올 때에 3억 9천에 팔았는데. 추억으로 찾았다가 속만 쓰린채 돌아왔다.
<참고 문헌>
홍승범, 김대호. 2014. 세면대 실리콘에 발생한 곰팡이의 동정. 한국균학회지. 42: 69-73.
Moriyama Y., Nawata N., Tsuda T., Nitta M. 1992. Occurrence of Molds in Japanese Bathrooms. International Biodeterioration & Biodegradation 30: 47-55.
oHara N., Ishiki S., Hamada N. 2009. Effect of Hypochlorite on the fungal contamination in the silicone in bathrooms. Journal of Antibacterial and Antifungal Agents. 37: 91-97.
Nicomedes V., Sutton D., Jose C., katihusak P., Nathan W., Josep. G., Alberto S. 2016. Colemycetous fungi in the clinical setting: Morphological convergence and cryptic diversity. Journal of Clinical Mycology 55: 552-567.
Aveskamp. M.M., Gruyter J., Woubenberg J.H.C., Verkley G.J.M., Crous P.W. 2010. Highlights of the Didymellaceae: A polyphasic approach to characterise Phoma and related pleosporalean genera. Studies in Mycology 65: 1-60.
Chen Q., Jiang J.R., Cai L., Crous P.W. 2015. Resolving the Phoma enigma. Studies in Mycology. 82: 137-217.
Chen Q., Hou L.W., Duan W.J., Crous P.W., Cai L.2017. Didymellaceae revisited. Studies in Mycology. 87: 105-159.